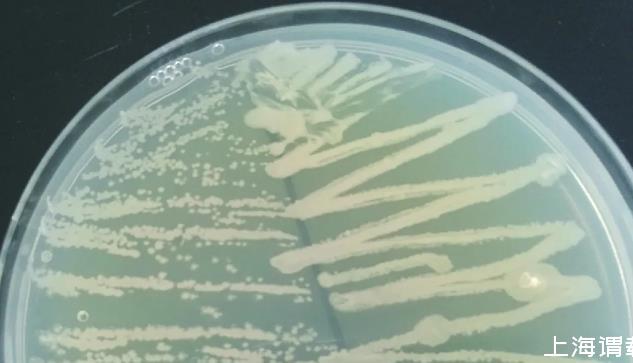

嘔吐毒素又叫什么?降解嘔吐毒素菌株特征、危害研究
嘔吐毒素,又名脫氧雪腐鐮刀菌烯醇(deoxynivalenol),是一種主要由禾谷鐮刀菌(Fusariumgraminearum)、粉紅鐮刀菌(F.roseum)和擬枝鐮刀菌(F.sporotrichioide)等鐮刀菌產生的真菌毒素。嘔吐毒素在被污染的小麥、玉米、大豆等糧食中廣泛存在,是食品和飼料中較常見的真菌毒素之一。該毒素能通過影響免疫細胞增殖和免疫細胞因子生成從而降低機體的免疫力;還可抑制mRNA翻譯和調節蛋白激酶活性,從而加速細胞凋亡,嚴重危害人和動物健康。1998年嘔吐毒素被國際癌癥研究機構列為3類致癌物。因此,采取有效措施去除小麥、玉米等糧食和飼料中的嘔吐毒素,保障食品和飼料安全,對人和動物健康具有重要意義。
由于嘔吐毒素的化學結構穩定,導致該毒素很難在加熱等處理中被破壞和去除。目前常用的脫除方法主要分為物理法、化學法和生物法,其中物理和化學方法脫除效果不穩定,同時還會破壞糧食中的營養物質,并且容易引入新的污染物。生物法主要是利用微生物產生的酶降解嘔吐毒素,該方法具有效率高、專一性強、環保等優點,受到廣泛關注,因此微生物降解已成為研究的熱點。本試驗從小麥田土壤中分離到一株高效降解嘔吐毒素的菌株,并對其降解特征進行了研究,為其應用于嘔吐毒素的脫除奠定了基礎。
1材料與方法
1.1試驗材料
土壤樣品采集自山東省青島市小麥地;鄰苯二甲酸二正辛酯購自國藥集團化學試劑有限公司;嘔吐毒素標準品購自以色列Fermentek公司;Super GelRed熒光染料購自US Everbright Inc.;嘔吐毒素ELISA試劑盒購自北京華安麥科生物技術有限公司。
1.2培養基
液體初篩培養基(g/L):0.25 g KH2PO4,0.25 g MgSO4·7H2O,0.5 g KNO3,0.5 g(NH4)2SO4,0.005 g CaCl2,0.003 g FeCl3·6H2O,2.0 g鄰苯二甲酸二正辛酯,pH 7.0,高壓滅菌15 min。
固體初篩培養基:初篩培養基加入2%瓊脂粉。
復篩培養基(g/L):10 g蛋白胨,3 g牛肉膏,10 g NaCl,1 g KH2PO4,1 g葡萄糖,pH 7.0,高壓滅菌15 min。
1.3降解嘔吐毒素菌株的初篩
取2 g土壤樣品于200 mL無菌水中,渦旋振蕩后取300μL懸液至300 mL液體初篩培養基中,37℃恒溫振蕩培養一周左右。當培養基出現渾濁后,在固體初篩培養基進行多次劃線純化,放置于37℃生化培養箱中培養。
1.4降解嘔吐毒素菌株的復篩
將初篩獲得的菌株接種于復篩培養基,37℃搖床發酵48 h。取發酵菌液1 980μL,加入20μL嘔吐毒素標準品(濃度為200 mg/L),使最終體系中嘔吐毒素含量為2 000μg/L,以加入同樣濃度嘔吐毒素的空白發酵培養基作為對照。37℃孵育48 h后,采用嘔吐毒素ELISA試劑盒檢測嘔吐毒素含量。降解率計算公式為:
y(%)=(1-S/C)×100。
式中,y是嘔吐毒素降解率,C是空白對照樣品中嘔吐毒素含量,S是處理樣品中嘔吐毒素含量。
1.5菌種鑒定
1.5.1生理生化特征于37℃培養箱對嘔吐毒素降解率最高的菌株進行培養,16 h后觀察菌落形態、色澤。觀察菌株革蘭氏染色反應及其氧化酶、過氧化氫酶等活性。
1.5.2細菌16S rRNA基因的擴增及分析取10 mL菌株發酵液,利用細菌DNA提取試劑盒提取基因組DNA。采用通用引物27F和1492R,利用PCR儀擴增16S rRNA基因。取5μL PCR產物上樣于1.0%瓊脂糖凝膠,電泳結束后通過凝膠成像系統觀察PCR擴增產物,片段大小合理的產物送測序公司測序。測序獲得的16S rRNA基因序列在EzTaxon-e server中進行比對分析,然后用MEGA X軟件構建系統進化樹。
1.6降解特性分析
對10 mL發酵菌體進行高速離心,制備胞外上清液。無菌水沖洗菌體后,加入10 mL無菌水制備菌懸液。通過超聲破碎菌懸液,再經高速離心和0.22μm無菌濾膜過濾獲得胞內液。上清液、菌懸液、胞內液3種組分中分別加入嘔吐毒素,37℃孵育48 h,利用試劑盒檢測各組分去除嘔吐毒素的效果。
1.7對小麥樣品中嘔吐毒素的降解
將嘔吐毒素超標的小麥樣品經研磨、滅菌,再經40℃干燥至恒重,測量其嘔吐毒素的含量。取菌株發酵液,與上述嘔吐毒素超標的小麥樣品按照5∶1(體積質量比)混合;以添加等體積液體培養基的小麥樣品作為空白對照,37℃孵育48 h,測量樣品中嘔吐毒素的殘留量。
2結果與分析
2.1降解嘔吐毒素菌株篩選
由圖1可知,菌株QD11、QD12、QD36、JJ15、ZJ4、ZJ5均能降解35%以上的嘔吐毒素,其中菌株QD36的降解率最高,為84.6%。因此選擇菌株QD36進行下一步研究。

圖1各菌株降解嘔吐毒素的能力
2.2菌種鑒定
2.2.1菌株QD36生理生化特征菌株QD36在固體LB平板中生長較快,菌落凸起,乳白色,不透明,呈現皺褶(圖2),該特征是芽孢桿菌的典型特征之一。革蘭氏染色呈陽性,具有氧化酶和過氧化氫酶活性。
圖2菌株QD36的菌落形態
2.2.2菌株QD36的16S rRNA基因鑒定利用凝膠成像系統觀察16S rRNA基因的PCR產物,在約1 500 bp處獲得一條特異性擴增條帶。測序結果表明菌株QD36與芽孢桿菌屬的菌株處于同一大的分支,其中與標準菌株BacillussiamensisPD-A10T聚類在一起,相似度高達99.9%。結合生理生化特征和16S rRNA基因分析結果,菌株QD36被命名為暹羅芽孢桿菌QD36(BacillussiamensisQD36)。
1,2:菌株QD36的16S rRNA基因;M:DL2000 DNA Marker。
2.3菌株QD36降解特性
比較菌株QD36不同組分去除嘔吐毒素的能力,上清液、菌懸液、胞內液可分別去除84.1%、13.9%和6.5%的嘔吐毒素。該結果表明菌株QD36分泌至胞外的活性物質主導嘔吐毒素的生物降解。
Bacillussiamensis:暹羅芽孢桿菌;Bacillusvanillea:香草芽孢桿菌;Bacillusvelezensis:貝萊斯芽孢桿菌;Bacillusamyloliquefaciens:解淀粉芽孢桿菌;Bacillusnakamurai:中村芽孢桿菌;Bacillusthuringiensis:蘇云金芽孢桿菌;Bacillusmycoides:蕈狀芽孢桿菌;Bacilluscirculans:環太芽孢桿菌;Bacilluscoagulans:凝結芽孢桿菌;Alicyclobacillusacidocaldarius:酸熱脂環酸桿菌。
2.4菌株QD36降解小麥中嘔吐毒素試驗
以嘔吐毒素超標的小麥樣品為研究對象,經48 h處理后,空白對照樣品S1的嘔吐毒素含量為2 530μg/kg,加入菌株QD36處理的樣品S2嘔吐毒素含量為456μg/kg,降解率為82.0%。以上結果表明,菌株QD36能顯著降解小麥樣品中的嘔吐毒素,具有去除嘔吐毒素的潛力。
3討論與結論
被嘔吐毒素污染的小麥、玉米等糧食和飼料嚴重危害人和動物健康。由于物理、化學處理方法有多種缺點,因此生物法去除嘔吐毒素越來越受到研究人員的重視。梁含等篩選了3株嘔吐毒素降解菌,分別是解淀粉芽孢桿菌、枯草芽孢桿菌、植物乳酸菌,其中枯草芽孢桿菌和植物乳酸菌組合對麩皮發酵處理可降解71%的嘔吐毒素。李曉鳳等從土壤中篩選了一株腸桿菌,可降解40.4%的嘔吐毒素。譚劍等篩選到一株枯草芽孢桿菌,該菌發酵液可降解玉米漿中80%的嘔吐毒素。余祖華等篩選到一株蠟樣芽孢桿菌,可降解飼料中82.68%的嘔吐毒素。付苗苗等從土壤中篩選到一株膿桿菌,可降解64.6%的嘔吐毒素,起降解作用的物質主要存在于發酵上清液中。
本研究通過初篩和復篩從青島小麥地土壤中篩選到多株降解嘔吐毒素的菌株,其中菌株QD36具有較強的降解能力,可降解84.6%的嘔吐毒素,相對于已報道的多株降解菌株,該菌降解效率較高;結合生理生化特征和16S rRNA基因測序結果,菌株QD36鑒定為暹羅芽孢桿菌(Bacillussiamensis)。該菌株對嘔吐毒素降解的活性物質主要存在于上清液中,具有很好的應用潛力。本研究為去除糧食和飼料中的嘔吐毒素提供了菌種資源。
相關新聞推薦
2、滸苔多糖降解微生物采集、分離、篩選、鑒定及生長曲線測定(四)
3、畢赤酵母植酸酶發酵工藝優化:比生長速率多少時甲醇流加補料效果最為理想?
